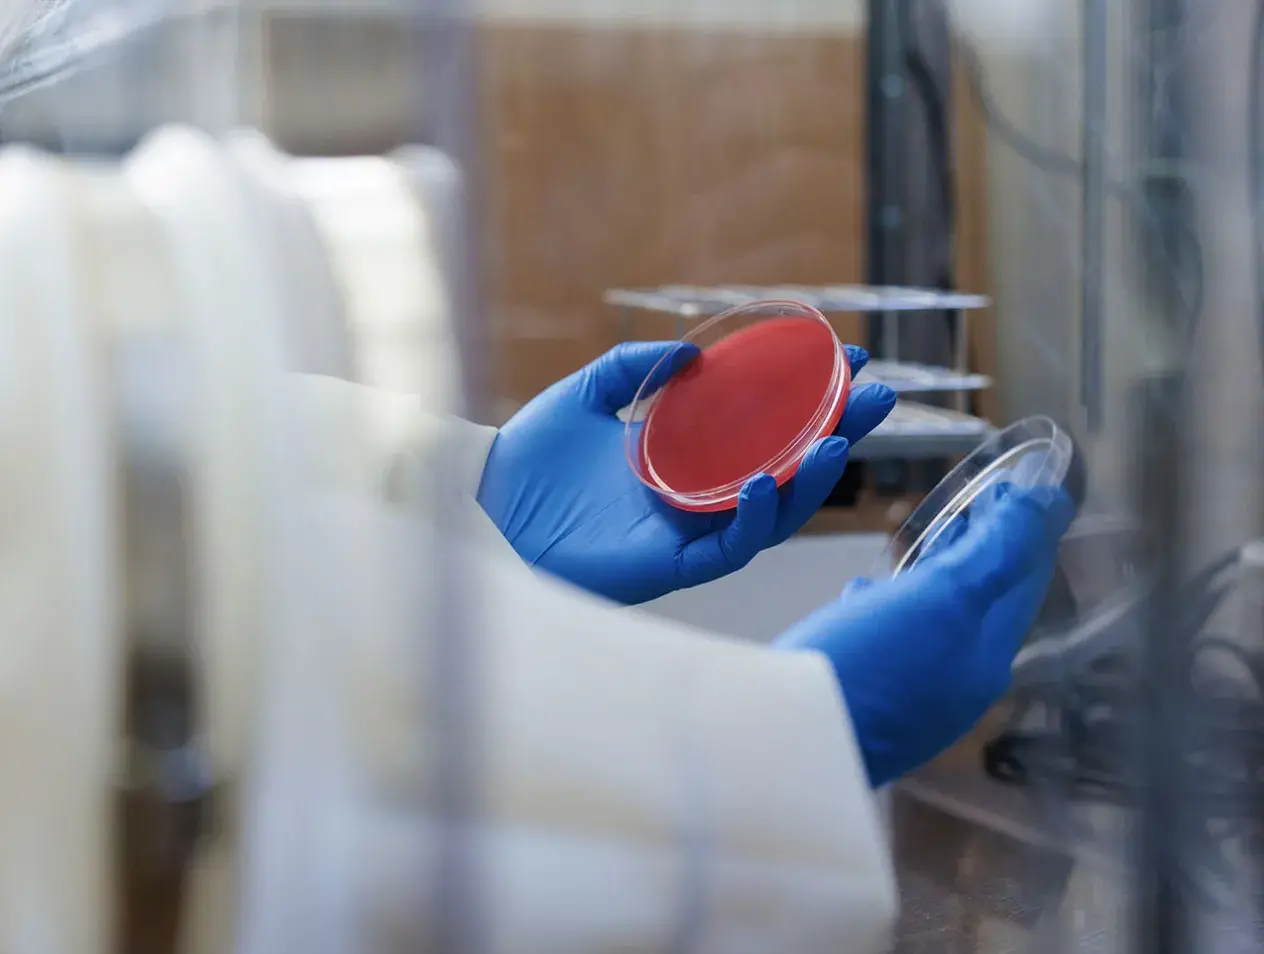

Antimicrobial Agents and Chemotherapy Minicourse
Upcoming Course Dates:
May 12-14, 2026
For general information and details regarding the course, contact Stacey Morrow MS, MT (ASCP) in the laboratory of Dr. Nancy Hanson:
StaceyMorrow@creighton.edu
Telephone: 402.280.3180
About the Minicourse
- Due to constraints on space for the laboratory portion of the course, enrollment is limited to 55 participants.
- The course is held in the Criss II building on the Omaha campus of Creighton University School of Medicine.
- Details regarding course information, registration, hotels, and a campus map can be found here.
Contact Us
Nancy D. Hanson, PhD
Professor and Director
ndhanson@creighton.edu
Stacey Morrow, MS, MT (ASCP)
Associate Director of Molecular Biology for the center
staceymorrow@creighton.edu
Travis Bourret, PhD
Associate Professor
Pathogenesis of parasitic and gram-negative bacterial infections
Richard V. Goering, PhD
Professor
Genetics of antibiotic resistance, epidemiological typing of bacterial strains
Nicholas T. Streck, PhD D(ABMM)
Assistant Professor, Department of Pathology
Clinical Microbiologist, Creighton University Medical Center - Bergan Mercy Hospital
Clinical microbiology and infectious disease
Patrick C. Swanson, PhD
Professor and Director of Flow Cytometry Core Facility
Protein expression and purification, antibody development and testing- lymphocyte development and function in animal models
Flow cytometry applications and analysis